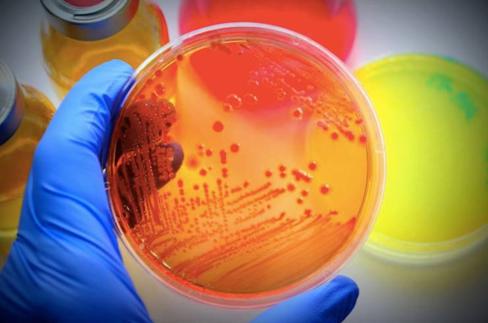
宝来利来生物科技有限公司,宝来利来生物产业园项目位置

近日,由省科学技术情报研究院、青岛市科学技术信息研究院联合开展了山东专利创新企业百强评选工作,发布《山东专利创新企业百强(2019)报告》。
山东宝来利来生物工程有限公司进入专利创新企业百强名单第一梯队!作为一家国家高新技术企业,山东宝来利来生物工程有限公司一直建设和打造核心人才队伍,追求科技创新,以行业科技领跑者的定位自我要求。本次评价指标体系跟以往相比,能够与海尔、海信这样的企业比肩,更加体现了企业专利的价值与影响力。
消息公开以来,多位企业家来电祝贺,表达他们对宝来利来的关心和支持。同时,在2020年禁抗的大环境下,许多人向宝来利来咨询微生态技术无抗养殖解决方案,以寻求深度合作。在这里,宝来利来愿意跟大家一起分享和解读:到底有哪些技术可以助力无抗养殖,究竟有哪些技术创新能够把宝来利来送进专利百强第一梯队!

多种专利益生菌,覆盖畜牧养殖各个环节
益生菌的作用非常广泛,早已在营养调控、免疫增强、防治感染和环境净化等畜禽和水产养殖的各个环节广泛应用。然而,益生菌的作用却千差万别,即使同一菌种的不同菌株,作用也不会相同。宝来利来根据“内调肠道,外控环境”的健康养殖理念,并结合畜牧业疫病多发和禁抗难题,通过航天育种、理化诱变、极端环境选育和基因工程改造等技术,筛选到多种具有特定功能的益生菌菌株,并获得国家专利授权。

专利技术促进营养吸收,增强健康、提高效益
针对饲料营养物质的有效利用,宝来利来研制出降低抗营养因子、促进蛋白质、脂肪和微量元素有效利用的枯草芽孢杆菌、乳酸菌和酵母菌,全面提高畜禽消化吸收和营养水平,增强机体健康、提高生产效益。其中,降解棉酚能力、有机硒、有机铁和促进脂肪代谢的专利菌株均达到行业领先水平。
增强免疫是最有效的抗感染办法
在增强畜禽免疫功能方面,宝来利来拥有高效肠黏膜粘附、促进肠上皮细胞修复、清除毒素、抗氧化、促免疫等多种功能的专利益生菌。通过定植抗力和修复受损的肠道黏膜,增强肠道黏膜免疫;通过降低肠道毒素、清除机体自由基,达到增强机体全身免疫、预防病原体感染的功效。
抗感染技术保护无抗时代下的易感动物
抗感染微生态制剂的研制,一直是宝来利来集中突破的重点。采用体内和体外综合评价的方法,筛选到具有较强抑菌作用的枯草芽孢杆菌、凝结芽孢杆菌和丁酸梭菌,有效抑制常见的病原微生物如大肠杆菌、沙门氏菌、金黄色葡萄球菌和产气荚膜梭菌等。此外,宝来利来已经突破针对多种病毒感染的微生态制剂技术,目前,这些抗感染专利益生菌均已转化成产品。在饲料业禁抗的今天,这些技术犹如一个个防护盾,有效防治畜禽感染,此类产品也是炙手可热。

改善养殖环境,增强畜禽健康
在功能益生菌的基础上,合理配伍各种有效成分,筛选出具有环境改良和净化效果的复合微生态制剂,并申请多项国家发明专利保护。其中,针对畜禽养殖环境净化和粪污处理技术,一种复合除臭剂的制备方法和应用也获专利授权,可以有效降解粪便中恶臭物质,改善畜禽舍环境、保障生物安全、增强机体健康水平。此外,在水产养殖方面,具有溶藻能力和增氧效果的复合微生态制剂与噬菌体技术的联合应用,可有效改善水体环境,提高鱼虾存活率。

方便终端客户自行发酵,降本增效
针对终端客户,在微生物发酵技术领域,反复筛选菌种,并联合多步发酵工艺,开发出具有高效发酵多种饲料原料的复合菌剂,这一技术的发明,大大方便了饲料厂和养殖终端自行发酵饲料和饲料原料,不仅大幅降低成本,还能够最大程度地发挥益生菌活菌制剂的作用。同时,宝来利来通过将现代微生物技术与传统中草药技术相结合,开发出发酵中草药复合微生态制剂,可大大提高药效,增强动物机体的免疫力和抗病能力。
专利技术为消费者提供安全健康的食品
针对广大消费者,随着人们对生物安全和食品安全诉求的升级,安全生产和无药物残留的肉蛋奶成了必然的追求。宝来利来在增强动物健康、防治动物疾病和提高动物产品品质方面做了大量的工作。开发出无抗养殖整体解决方案,帮助顾客生产有机畜产品、提高蛋品质和奶品质、打造无抗有机品牌的肉、蛋、奶。此外,针对水产动物,宝来利来拥有提高鱼虾类水产品蛋白含量的先进生物技术,并获得国家授权的发明专利。